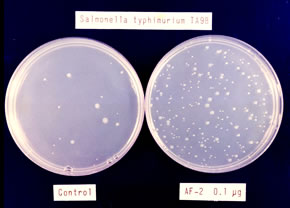
変異原性試験の写真

労働者健康安全機構 トップページ > 研究事業 > 化学物質等の有害性調査 >

四塩化炭素を2年間吸入したマウスにみられた
肝細胞癌(肝臓顕微鏡写真)
化学物質を動物に投与し、投与により増加した病態を詳細に調べ、記録します。実験動物は、投与した化学物質以外の影響を排除するために、クリーン度の高い状態を保った特殊な飼育施設内において、温度と湿度を一定に維持し、照明時間も管理した環境で飼育します。
遺伝毒性試験は、遺伝子に対する障害性を評価するものです。一塩基から染色体のレベルまでの種々の変異を評価する試験法があります。
